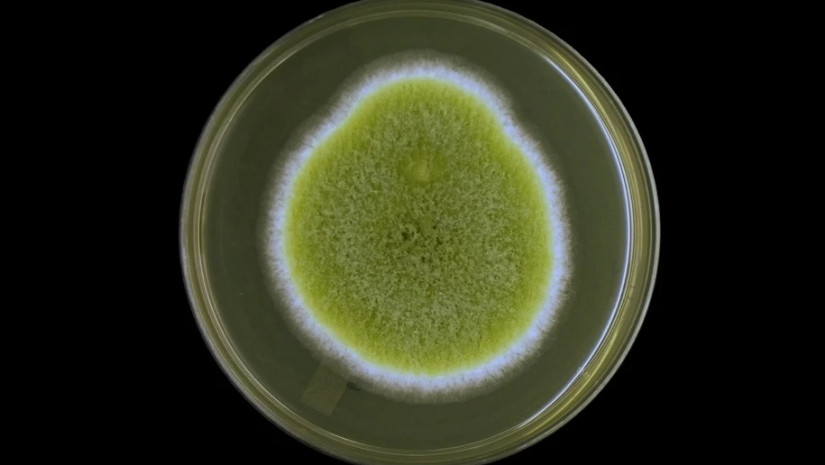

ობის სოკო, რომელმაც სავარაუდოდ ტუტანხამონის აკლდამის გამხსნელი რამდენიმე ადამიანის სიკვდილი გამოიწვია, შესაძლოა, იმედისმომცემ საიდუმლოს მალავდეს.
სოკოს ეს სახეობა, Aspergillus flavus-ი, ფარაონის წყევლა არა, მაგრამ სამედიცინო დალოცვა იყოს.
პენსილვანიის უნივერსიტეტის მოლეკულური ინჟინრების მიერ ჩატარებული ახალი კვლევის თანახმად, ეს კონკრეტული სოკო კიბოს საწინააღმდეგო ნაერთებს შეიცავს.
ლაბორატორიაში, როდესაც მისი ბუნებრივი პროდუქტები ადამიანის ლეიკემიის უჯრედებს შეურიეს, ძლიერი ეფექტი აჩვენეს. მოდიფიცირების შემდეგ კი ზუსტად ისე კარგად იმუშავეს, როგორც ქიმიოთერაპიულმა პრეპარატებმა.
ამ ნაერთებს RiPP-ს უწოდებენ (ribosomally synthesized and post-translationally modified peptides) და მათ სხვადასხვა ორგანიზმები წარმოქმნიან, მათ შორის, მცენარეები და ბაქტერიები.
ბოლო წლებში, მცენარეებისგან მიღებულმა RiPP-ებმა დიდებული პოტენციალი აჩვენა ზოგიერთი ტიპის კიბოსთან ბრძოლაში, მაგრამ სოკოვანი წარმოშობის RiPP-ები ასე კარგად შესწავლილი არ არის და უნიკალური სტრუქტურის გამო, შეიძლება მოხდეს მათი არასწორი იდენტიფიცირება.
„მიუხედავად იმისა, რომ მხოლოდ რამდენიმეა აღმოჩენილი, თითქმის ყველა მათგანს აქვს ძლიერი ბიოაქტიურობა. ეს გახლავთ შეუსწავლელი რეგიონი უზარმაზარი პოტენციალით“, — ამბობს კვლევის ავტორი, პენსილვანიის უნივერსიტეტის ბიომოლოკულური ინჟინერი ქიუე ნიე.
A. flavus-ი მთელ მსოფლიოში გვხვდება გახრწნილ ორგანულ მასალებში; მისმა ყვითელ-მწვანე სპორებმა შეიძლება დააინფიციროს როგორც სასოფლო-სამეურნეო კულტურები, ისე ძუძუმწოვართა ფილტვები. ადამიანებში, ასპერგილოზის ინფექციამ შეიძლება გამოიწვიოს ფილტვის ქრონიკული დაავადება, რომელიც მკურნალობის გარეშე ფატალურადაც შეიძლება დასრულდეს.
1973 წელს, მეცნიერთა ნაწილი, რომლებმაც პოლონეთის მეფე კაზიმირ IV იაგიელონის სამარხი გახსნეს, ნაადრევად დაიღუპა. მაშინ მიკრობიოლოგებმა სამარხში A. flavus-ს მიაკვლიეს, რომელმაც გააჩინა ვარაუდი, რომ სწორედ ის გახდა მკვლევართა სიკვდილის მიზეზი.
ეს ლოგიკა მოარგეს მეოცე საუკუნის დასაწყისში, ფარაონ ტუტანხამონის აკლდამის გამხსნელი მუშებისა და გრაფის უცნაურ სიკვდილს. გრაფი რამდენიმედღიანი ავადმყოფობის შემდეგ დაიღუპა, მუშები კი წლების შემდეგ.
ამ სიკვდილებში Aspergillus-ის როლმა მრავალ წარმოსახვას დაუდო საფუძველი. ისტორიის წიგნებში ამ სოკოს პოპულარობამ თანამედროვე ეპოქაში უკვე მისი სამეცნიერო ყურადღების ცენტრში მოქცევა განაპირობა.
ნიე და მისი კოლეგები A. flavus-ის კიბოს საწინააღმდეგო მოქმედების შესახებ ჩატარებულმა კვლევებმა შთააგონა, რათა Aspergillus-ის ათეულობით შტამი RiPP-ებზე შეემოწმებინათ.
მეტაბოლური და გენეტიკური მეთოდების გამოყენებით, მათ ყურადღება გაამახვილეს ოთხ სხვადასხვა გაწმენდილ ნაერთზე, რომლებსაც მსგავსი, კომპლექსური სტრუქტურები ჰქონდათ. მათ ასპერიგიმიცინები უწოდეს.
ვრცლად პირველ არხზე